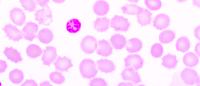
red blood cells infected with malaria parasite

New Insights into Malaria Could Reshape Treatment
New discoveries about the malaria parasite made by researchers at Columbia and Drexel universities could change the way malaria is treated in the future.
As malaria parasites around the world become resistant to anti-malarial drugs and progress against the disease stalls, researchers are looking for new compounds to kill the parasites. A sodium pump essential to the parasite’s survival, PfATP4, has emerged as one of the most attractive drug targets, but parasites have rapidly developed resistance to experimental PfATP4 inhibitors.
The new study provides researchers with critical information about PfATP4 that could bring about more durable inhibitors. The study presents the first high-resolution 3D structure of PfATP4—revealing new sites where inhibitors could bind—and identifies a previously unknown but essential binding partner, opening an entirely new avenue for anti-malarial drug development.
The first high-resolution 3D structure of P. falciparum's PfATP4 sodium pump, shown here with a newly discovered binding protein PfABP, could lead to new treatments for malaria. Image from Haile et. al (2025) Nat Comm 16:9092.
“Every year, malaria parasites adapt to outsmart our medicines. With the structure of PfATP4 now in hand and the discovery of this unknown partner, we have identified vulnerabilities that can be exploited for new therapies,” says Chi-Min Ho, co-senior author and assistant professor of microbiology and immunology at Columbia University Vagelos College of Physicians and Surgeons.
The new research underlines the importance of studying the malaria parasite in its natural host cell. Previous attempts to elucidate the 3D structure of PfATP4 have followed standard procedures for structural studies: Researchers first insert a gene into a yeast or bacteria cell, culture the cells to create enough copies of the gene’s protein for analysis, and then obtain images of the proteins using cryo electron microscopy.
But expressing P. falciparum genes in cells other than the parasite’s natural hosts often fails.
Several years ago, Ho pioneered techniques that allow researchers to obtain high-resolution 3D structures of P. falciparum proteins isolated directly from parasite-infected blood cells.
In the new study, the research team used Ho’s innovative techniques and the resources of the Columbia Electron Microscopy Center to successfully visualize the PfATP4 sodium pump, allowing the scientists to precisely map where clinically relevant resistance mutations occur.
“The findings provide a blueprint for next-generation drug discovery, offering ways to design molecules that target PfATP4,” says Akhil Vaidya, co-senior author and professor of microbiology and immunology at Drexel University College of Medicine.
Unexpectedly, the images also revealed a previously unknown protein bound to the pump. The new protein, which the researchers named PfATP4 Binding Protein (PfABP), appears to stabilize and regulate PfATP4’s function and is essential for parasite survival.
“We found that loss of PfABP led to the rapid degradation of the PfATP4 sodium pump and death of the parasite,” says co-first author Meseret Haile, a PhD student in the Microbiology, Immunology, and Infection program at Columbia’s Vagelos College of Physicians and Surgeons. “Because PfABP seems to be less prone to mutations, drugs that target it may be harder for parasites to evade.”
Ho says that the discovery of the binding protein would not have been possible without techniques that allow the parasite’s proteins to be studied in their natural state.
“These endogenous methods allow us to understand proteins as they exist in their cellular milieu and enable the discovery of completely new biology,” Ho says.
References
More information
Anurag Shukla, co-first author, is a research instructor at Drexel University College of Medicine.
All authors: Meseret T. Haile (Columbia), Anurag Shukla (Drexel), James Zhen (Columbia), Michael W. Mather (Drexel), Suyash Bhatnagar (Drexel), Joanne M. Morrisey (Drexel), Zhening Zhang (Columbia), Akhil B. Vaidya (Drexel), and Chi-Min Ho (Columbia).
The research was supported by grants from the U.S. National Institutes of Health (DP5OD029613, R01AI132508 and R01AI154499).